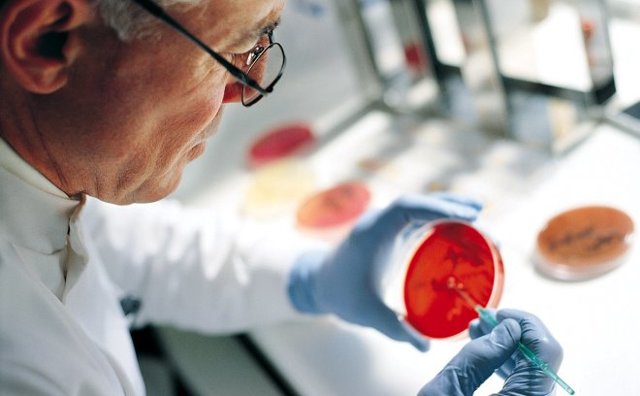
Плохая свертываемость крови при беременности чем грозит ребенку - Все про гипертонию

При беременности увеличивается свертываемость крови. Скорее всего, это происходит в женском организме как мера предосторожности, позволяющая избежать чрезмерную кровопотерю во время родов. Так, количество белка, отвечающего за свертываемость, возрастает. Опасно ли для беременной женщины сгущение крови? Поговорим о симптомах, рисках и профилактике гиперкоагуляции.
Почему возникает повышенный риск свертывания крови
Сгустки крови образуются тромбоцитами в месте повреждения тканей, чтобы уменьшить кровотечение. Но во время беременности под действием эстрогена кровь сгущается и может произойти ряд серьезных проблем со здоровьем.
Не зря специалисты называют беременность протромботическим состоянием с изменением фибринолиза (способности разрушать кровяные сгустки).
Патология возникает чаще всего в первые 3 месяца беременности (около 50% всех случаев приходится на 15 недель) или первые 6 недель после родов, затрагивая 1 или 2 беременных на каждые 2000 человек.
Признаки гиперкоагуляции
Быстрая коагуляция – осложнение, имеющее угрозу для жизни роженицы. Так, при повышенной свертываемости крови у некоторых женщин возникает:
- Венозный тромбоз, который проявляется острой болью, судорогами и отеком в одной или обеих ногах, вздутием вен, покраснением или посинением кожи, жжением в пораженном участке. Следует отметить, что боль длительно не проходит. Интересно отметить и то, что примерно 80% тромбоза глубоких вен приходится на левую ногу. Это связано с анатомией кровоснабжения ног и частично с давлением матки.
- Легочная эмболия, для которой характерна одышка, боль в груди, усиливающаяся при глубоком вдохе, кашель (иногда с кровью), учащенный пульс, затрудненное дыхание, цианоз и даже потеря сознания. Это состояние требует срочной госпитализации.
- Выкидыш из-за антифосфолипидного синдрома, при котором кровяные сгустки образуются в сосудах, снабжающих питанием развивающийся эмбрион. В результате кровоснабжение плода уменьшается, что приводит к преждевременным родам и реже – к внутриутробной гибели ребенка.
- Отслойка плаценты – состояние, при котором плацента отслаивается от стенки матки частично или полностью до родов, вызывая сильное кровотечение, опасное для матери и ребенка.
Нельзя не сказать и о таких редких осложнениях, связанных с нарушением свертываемости крови у беременных, как инфаркт миокарда и инсульт.
Более всего подвержены риску тромбофилии женщины:
- старше 35 лет;
- курящие;
- с избыточным весом;
- путешествующие на большие расстояния;
- у которых уже были выкидыши;
- с генетической предрасположенностью к тромбозу;
- с многоплодной беременностью;
- после кесарева сечения;
- с гипертонией или преэклампсией;
- ведущие малоподвижный образ жизни.
Существуют ли какие-либо тесты на наличие тромбов?
Врач может просканировать пораженную область с помощью ультразвука или магниторезонансной венографии. Также пациентке может быть назначена флебография. Если есть подозрение на легочную эмболию, беременной проводят спиральную КТ (компьютерную томографию), электрокардиограмму сердца.
Способы лечения высокой свертываемости крови
В зависимости от тяжести состояния ваш участковый акушер-гинеколог направит вас к гематологу – врачу, который специализируется на диагностике и терапии заболеваний крови.
Как правило, беременным с патологией назначаются антикоагулянты (гепарин считается наиболее безопасным), предотвращающие образование тромбов в крови.
Даже если диагноз только подозревается, лечение начинают немедленно.
Если тромбы расположены ближе к поверхности кожи, то помогают также теплые компрессы, бинтование ног и поднятие их для снятия отека.
Профилактика заболевания заключается и в ведении активного образа жизни, регулярных упражнениях (с согласия врача), улучшающих кровообращение и препятствующих образование сгустков. Основная цель – поддерживать нормальный кровоток в организме. Что еще рекомендуют специалисты:
- питаться полезными продуктами и не допускать избыточной массы тела;
- не курить;
- пить больше воды;
- не сидеть без движения более 20 минут. Если вы вынуждены долго сидеть в поездке или на работе, каждые полчаса вставайте и по возможности перемещайтесь;
- уменьшить потребление соли;
- постараться не перекрещивать ноги, когда сидите.
- Принимая во внимание опасные для жизни последствия повышенной свертываемости крови, беременной следует выполнять все назначения врача!
- Похожие посты
- Оставить комментарий
Плохая свертываемость крови у беременных
Плохая свертываемость крови при беременности – состояние патологического характера, несущее риски для здоровья женщины и плода. При такой аномалии возрастает вероятность самопроизвольного прерывания беременности, сильных кровотечений при родовой деятельности.
Важно вовремя определить нарушение и оценить, насколько оно опасно при вынашивании малыша. Выявить патологические процессы помогут плановые исследования.
По результатам анализов врач определяет дальнейшую тактику ведения беременности, назначает лечение и дает рекомендации, направленные на приведение показателя свертываемости в норму.
Важно своевременно проводить исследование кровяной жидкости
Недостаточная коагуляция крови: определение понятия
Свертывание крови имеет второе название, процесс еще называют коагуляцией. Это – своеобразная защитная реакция организма. Если коагуляция в норме, то в сосудах находится нужное количество крови, что предотвращает кровопотери. Защитная реакция особенно важна при нарушении целостности сосудистого русла: так снижаются риски летального исхода от кровопотери.
При недостаточном сгущении крови наблюдается ферментативная недостаточность. Вещества, отвечающие за густоту крови, не могут обеспечить остановку кровотечения, что опасно для жизни человека. Во время вынашивания малыша свёртываемость крови повышается.
В норме повышение активности ферментов, отвечающих за густоту крови, происходит во втором триместре и продолжается до конца срока. Сама природа предусмотрела изменения. Без повышения коагуляции роды стали бы опасным процессом. Плацента обладает интенсивным кровотоком.
После отделения детского места кровотечение быстро прекращается только благодаря увеличению показателя свертываемости. Повышенная коагуляция – обязательное условие благополучного родоразрешения.
Опасность патологии
Недостаточная коагуляция опасна при вынашивании малыша. Когда патологическое состояние наблюдается на протяжении длительного срока, повышаются риски:
- самопрерывания беременности;
- отслойки плаценты (в 3-ем триместре);
- сильного кровотечения при родах.
Если случится кровотечение и его не удастся остановить на протяжении долгого времени, могут пострадать внутренние органы и суставы женщины, нарушиться системы жизнедеятельности. При снижении защитных реакций крови высока вероятность летального исхода во время родов.
Плохая коагуляция в материнском организме приводит к развитию патологий гемостаза у плода. После рождения у малыша могут диагностировать гемофилию либо тромбоцитопению разных форм. Часто параллельно развиваются аномалии органов, наблюдаются умственные отклонения.
Причины плохой коагуляции
Будущая мама должна следить за своим питанием
Почему кровь недостаточно сворачивается при беременности? Главной причиной такого явления считается снижение иммунитета, характерное для «интересного положения». Ослабление иммунных функций необходимо. Так организм не станет воспринимать плод в качестве чужеродного тела и не начнет отторгать его. Иногда иммунитет беременной снижается настолько сильно, что ухудшается коагуляция.
Патологическое состояние может возникнуть при нехватке витаминов и важных веществ (например, кальция, железа). На появление аномалии влияет неправильное питание: употребление продуктов с различными химическими добавками, консервантами. Ухудшение свертывания может наблюдаться на фоне вирусных инфекций и болезней печени. На коагуляцию негативно влияет бесконтрольный прием антибиотиков.
Вязкость крови значительно снижается при наличии генетического заболевания – гемофилии. При болезни даже неглубокий порез представляет опасность для жизни. Заболевание встречается редко.
Гемофилия имеет наследственный характер, поэтому женщина к моменту зачатия знает о своей болезни.
Пациентки с таким диагнозом и женщины-носители генетической аномалии обязательно должны планировать потомство: дефицит факторов, отвечающих за коагуляцию, требует особого плана ведения беременности. При тяжелых формах гемофилии беременность и вовсе невозможна.
Симптомы недостаточной свертываемости
Симптомы плохого свертывания крови у беременной могут отсутствовать практически до момента родов. Это усложняет диагностику патологии.
Будущей маме может казаться, что с ее организмом все в порядке, ведь признаков аномалии длительное время не наблюдается. При отклонении от нормы система свертываемости меняется постепенно.
Когда патологические изменения нарастают, появляются специфические признаки, по которым можно определить аномалию. Когда стоит волноваться? На плохую коагуляцию указывают:
- подкожные гематомы, появляющиеся от любого прикосновения;
- частые носовые кровотечения;
- кровоточивость десен;
- кровяные примеси в моче;
- ранки/микротрещины на коже;
- замедленная остановка кровотечения из ран.
При любых подозрительных признаках стоит обратиться к врачу
Если проигнорировать первые признаки, развивается клиническая картина, схожая с клиникой анемии. Беременная все время чувствует слабость, быстро устает, частыми спутниками становятся головокружения и мигрени. Изменения видны и по внешнему виду:
- ногти становятся очень хрупкими и все время ломаются;
- волосы теряют свою привлекательность и выпадают;
- слизистая оболочка нижнего века становится бледной.
Будучи в «интересном положении» важны любые сигналы организма. Появление хотя бы одного настораживающего признака – повод обратиться к врачу. Раннее определение плохой коагуляции позволяет оперативно принять меры, направленные на повышение густоты крови. Это поможет нивелировать риски, с которыми сопряжена патология.
Диагностика отклонения
Определить, что кровь плохо сворачивается, помогают плановые обследования будущей мамы. Анализ, позволяющий отследить коагуляцию, называется коагулограмма. Сдавать его нужно каждый триместр. Частота анализа может увеличиться при:
- оперативном вмешательстве любого вида;
- заболеваниях печени;
- аутоиммунных патологиях;
- сосудистых аномалиях.
Анализ назначают чаще чем три раза за срок, когда у беременной есть наследственная предрасположенность к плохой коагуляции. Если первая коагулограмма показала отклонения от нормы, то анализ придется сдавать часто. Это помогает отслеживать динамику отклонения, контролировать состояние матери и плода, оценить возможные риски и провести необходимые меры для исключения негативных последствий.
Расшифровка коагулограммы
Для определения уровня коагуляции требуется забор крови из вены. Анализ проводят натощак: между приемом пищи и сдачей крови должно пройти восемь часов. Коагулограмма имеет ряд показателей, значение которых важно знать:
- АЧТВ – временной показатель. Это – срок формирования сгустка крови после добавления к плазме специальных реагентов. В норме сгусток формируется примерно за двадцать секунд. При значительном снижении показателя высока вероятность образования тромбов, при повышении – кровотечений.
- Волчаночный коагулянт – показатель антител. В норме антитела отсутствуют. Их вырабатывает иммунитет против кровяных ферментов. Наличие такого показателя в коагулограмме свидетельствует о повышенном риске самопрерывания беременности, вероятности тромбоза.
-
Только врач может правильно расшифровать результаты анализов
Фибриноген – специфический белок, задействованный в тромбообразовании. К концу вынашивания показатель может достигать 6,5 г/л, но не превышать эту цифру. - Тромбоциты – элементы крови, вырабатываемые костным мозгом. В пределах нормы максимумом считается 402, минимумом – 131 тыс./мкл.
- Протромбин – показатель белка плазы, должен составлять 78 – 142%.
Показатели коагулограммы напрямую связаны со сроком гестации. Они могут меняться. В разных триместрах и при наличии ряда факторов небольшие «сдвиги» в одну из сторон могут считаться вариантом нормы. Расшифровкой анализа должен заниматься исключительно врач. Делать поспешные выводы, имея на руках результаты исследования, будущей маме не стоит.
Лечение плохой свертываемости
Если анализ покажет, что кровь у будущей мамы свертывается плохо, обязательно проводится коррекция такого состояния. Лечение призвано улучшить коагуляцию, что позволяет исключить риски для беременной и плода. Коррекционные меры в каждом конкретном случае определяет врач-гематолог.
Он подбирает индивидуальную программу, учитывающую масштаб проблемы, наличие у пациентки хронических заболеваний, генетической предрасположенности к нарушениям гемостаза. Если нарушение в кровяной системе вызвано определенной болезнью (например, печеночными заболеваниями), то при возможности проводят устранение основной патологии.
Это исключит ухудшение коагуляции до конца вынашивания.
Коррекция свертываемости обычно проводится с применением лекарственных препаратов. Врач назначает лекарства, благотворно влияющие на систему крови, и не имеющие противопоказаний для приема в период вынашивания.
Принимая препараты, которые назначил доктор, будущая мама может не бояться за собственное здоровье и за состояние малыша. Тщательно продуманная медикаментозная терапия повышает шансы на вынашивание, исключает возможность сильного кровотечения при родовой деятельности.
Дополнительно к препаратам, отвечающим за нормализацию коагуляции, врач может назначить витаминные комплексы, железосодержащие препараты.
Своевременное лечение поможет выносить и родить здорового малыша. Коррекция лекарственными препаратами должна осуществляться исключительно под контролем специалиста. Категорически запрещено принимать лекарства без консультации с врачом, ведь это может привести к непоправимым последствиям.
Коррекция с помощью продуктов
Правильно скорректировать рацион питания поможет диетолог
Если коагулограмма показала незначительные отклонения от нормы, то медикаментозная терапия может не потребоваться. Будущей маме придется просто пересмотреть свой режим питания. Существуют продукты, улучшающие коагуляцию. К ним причисляют:
- сливочное масло;
- жирные сливки;
- мясо жирных сортов;
- субпродукты;
- гречневая каша;
- зелень: базилик, петрушка, укроп;
- овощи: свекла, редька, редис, репа, краснокочанная капуста;
- ягоды: голубика, шелковица, ежевика, калина, красная/черная смородина;
- фрукты: манго, банан;
- бобовые: соя, горох, чечевица, фасоль.
Для нормализации гемостаза рекомендуется употреблять гранатовый сок либо сок из белого винограда. Помогут справиться с проблемой грецкие орехи. Незначительное отклонение требует изменения питьевого режима: жидкость разжижает кровь, поэтому количество выпитого нужно контролировать. От острого и пряного беременным стоит отказаться: такие продукты нарушают защитную функцию крови.
Коррекцию питания нужно проводить во взаимодействии с врачом. «Интересное положение» требует, чтобы рацион был сбалансированным и богатым на витамины. По поводу отказа от одних продуктов и введения в ежедневное меню других для повышения коагуляции нужно консультироваться с доктором.
Профилактические меры
При вынашивании ухудшение коагуляции наблюдается у многих. Не столкнуться с проблемой помогут простые профилактические меры. Беременной нужно уделять внимание укреплению сосудов. В этом помогут богатые на витамины продукты, соблюдение питьевого баланса, отказ от вредных привычек (курение, алкоголь).
Важно знать, какие продукты разжижают кровь, нарушая нормальную коагуляцию, и при повышенных рисках снизить их потребление. Например, к таким продуктам относят рыбу жирных сортов, овсяную крупу, оливковое масло, зеленый чай. Параллельно в рацион добавляют продукты, способствующие сгущению крови.
Для профилактики пьют отвары из шиповника и крапивы, однако о целесообразности применения народных методов нужно проконсультироваться с врачом.
Главной профилактической мерой является своевременная постановка на учет в женскую консультацию и сдача плановых анализов. Только так можно определить нарушения в кровяной системе.
Особенно это правило нужно соблюдать женщинам с хроническими заболеваниями, генетической предрасположенностью к болезням крови.
Своевременная диагностика и последующие за диагнозом меры помогут родить здорового малыша без рисков для здоровья мамы.
Плохая свертываемость крови при беременности
Беременность- несомненно, очень важный период в жизни каждой женщины. В это время происходят изменения в организме будущей мамы и ее внешности. Женщина должна следить за своим питанием, режимом дня и контролировать свои анализы. Одной из проблем, с которой сталкиваются будущие мамы, является проблема плохой свертываемости крови при беременности.
Плохая свертываемость крови при беременности: на сколько это может быть опасно для жизни матери и ребенка?
Плохую свертываемость крови другими словами называют тромбоцитопенией. Возникает она в следствии уменьшения количества тромбоцитов в крови.
Такая болезнь очень редко является наследственной или врожденной, в большинстве случаев она приобретенная. Больше склонны к этому заболеванию женщины.
Если тромбоцитопенией болеет беременная, то это может нарушать развитие малыша или, даже, привести к выкидышу.
Почему возникает тромбоцитопения?

Каждая женщина должна помнить, что обязательно необходимо планировать беременность, а для этого проходить обследования у врачей еще до зачатия, чтобы иметь возможность откорректировать любые изменения в своем организме.
Что же может спровоцировать плохую свертываемость крови у беременных? Есть несколько причин возникновения этого заболевания.
Если говорить о наследственной тромбоцитопении, то риск возникновения может быть у будущих мам, у которых:
- есть родственники переболевшие инсультом, инфарктом, тромбозом;
- по женской линии было варикозное расширение вен;
- беременность прерывалась естественным путем;
- есть нарушения кровеносной системы.
Приобрести тромбоцитопению будущая мама может:
- переболев вирусной инфекцией;
- принимая антибиотики;
- из-за недостатка витаминов;
- через интоксикацию;
- из-за употребления продуктов, которые имеют в своем составе консерванты или химические добавки.
Симптомы плохой свертываемости крови у будущей мамы
Основными симптомами тромбоцитопении у беременной женщины будут:
- кровоточивость десен;
- появление синяков на теле;
- частые кровотечения из носа.
Лечение тромбоцитопении
Когда беременная женщина начинает замечать у себя хоть один из симптомов возникновения плохой свертываемости крови, она должна немедленно обратиться за консультацией к своему врачу. Он, в свою очередь, обязан направить будущую маму на прием к гематологу.
Зачастую беременных женщин очень пугают любые медикаменты, которые им приходится принимать при вынашивании малыша. Препараты, которые способны нормализовать кровеносную систему, не окажут плохого влияния на будущего ребенка. Они, наоборот, помогут спасти малыша, а также избежать сильных кровотечений при родоразрешении.
Многие женщины задаются вопросом: возможно ли избежать тромбоцитопении при беременности? Конечно, возможно. Для этого необходимо заниматься укреплением сосудов. Помогут в этом случае народные рецепты из отваров крапивы и настоек шиповника. Положительно влияют на состав крови лимоны.
Употреблять их необходимо вместе с кожурой, добавляя мед. Укрепляет сосуды цитрин, именно его достаточно в цитрусовых.
Советуем также почитать: Эритроциты в моче при беременности
Что такое коагулограмма?
Все хорошо знают, что будущей маме приходится сдавать множество разных анализов, некоторые даже не один раз. Когда женщина слышит такое непонятное слово как коагулограмма, она приходит зачастую в ужас. Но ничего страшного в нем нет. Это только анализ крови, который обязателен в период вынашивания малыша. Что по нем можно узнать и когда его делать — попробуем сейчас разобраться.
Советуем к прочтению: Отекают ноги во время беременности, Отёк носа при беременности, Болят кости таза при беременности
Одним из самых главных показателей здоровья женщины является кровеносная система. Особое внимание ей надо уделять в период вынашивания ребенка. Анализ крови на коагулограмму дает возможность определить нарушения гемостаза — это система отвечающая за жидкое состояние нашей крови, а также за свертываемость.
Когда показатель гемостаза низкий, то женщина может терять много крови, даже тогда, когда делает небольшую царапину на теле. Если показатель очень высокий — это провоцирует возникновение тромбоза, инфаркта, инсульта.
Врачи считают любое отклонение от нормы опасным, так как в период нормальной жизни оно никак о себе не дает знать, а во время родов или операционного вмешательства, может привести к неожиданным критическим ситуациям.
Гемостаз беременной женщины немного меняется. Из-за этого анализ на коагулограмму до беременности и во время вынашивания ребенка не совпадает. Такие перестройки в организме женщины предусмотрены самой природой.
Когда будущая мама вынашивает малыша, в ее организме возникает еще один круг кровообращения — маточно-плацентарный.
Увеличивается количество крови, которая циркулирует, так как во время родов женщина теряет некое ее количество.
Когда нужно сдавать анализ на коагулограмму?
Коагулограмма проводится один раз на три месяца. Бывают случаи когда потребность такого анализа увеличивается. Чаще делают коагулограмму женщинам, у которых есть варикозное расширение вен, сосудистые и иммунные заболевания, в перед и послеоперационный период.
Если женщина имеет отрицательный резус-фактор, она находится в группе риска. При таком резусе, во время беременности, иммунитет мамы ведет борьбу с собственными антителами, так как способен воспринимать их как чужеродные.
Если у будущей мамы есть предрасположение к тромбоцитопении или же предыдущие анализы показали какие-либо отклонения от нормы, анализ приходится время от времени повторять. Кровь на коагулограмму берется из вены.
Перед анализом нельзя употреблять пищу на протяжении восьми часов.
Когда у женщины есть нарушения в свертываемости крови и это не было вовремя исследовано, то появляется очень высокий риск прерывания беременности, преждевременные роды, а также нарушения функций мозга будущего малыша.
Советуем также почитать: Температура тела при беременности
Как правильно расшифровать результаты анализа?
Важно запомнить, что расшифровывать анализы должен врач-специалист, так как они могут постоянно меняться. При хронических заболеваниях у будущей мамы могут быть отклонения от нормы по анализу, но вынашивание плода будет в норме.
Анализ на коагулограмму имеет в себе 8 показателей
- Фитриноген — или белок. Его норма — 2-4 г/л, а у будущих мам может быть даже 6 г/л. если показатель повышен, значит есть склонность к тромбозу. Если женщина страдает токсикозом — показатель может быть немного понижен. Важно помнить что количество фибриногена возрастает вместе с ростом малыша.
- АЧТВ — показатель промежутка, за который кровь может сворачиваться. У обычного человека это от 24 до 35 секунд. У будущей мамы — от 17 до 24 секунды. Все это происходит из-за увеличения фибриногена в крови.
- Тромбиновое время — это продолжительность последней свертываемости крови. Норма от 11 до 18 секунд.
У женщин, которые вынашивают ребенка это время намного больше. если есть отклонения, значит существуют проблемы в работе печени.
- Протромбины — белки, которые находятся в плазме крови. Норма — от 78% до 142%. Если уровень повышен, значит есть отслойка плаценты.
- Тромбоциты — элементы в косном мозге.
При беременности их уровень может немножко понижаться. Когда отклонение значительное, значит есть заболевания. В большинстве случаев снижение уровня тромбоцитов происходит из-за недостаточного питания и очень редко из-за развития ДВС-синдрома.
- D-димер. В ответе за тромбообразование. У будущей мамы такой показатель постепенно увеличивается.
Если увеличение стремительное — значит есть заболевание почек или сахарный диабет.
- Антитромбин III — берет участие в замедлении свертываемости крови. Когда женщина пьет медикаменты, которые направленны на снижение свертываемости, этот показатель необходимо постоянно держать на контроле.
- Группа специфических антител.
Если со здоровьем все в порядке этого показателя не должно быть. Наличие говорит о гистозе.
Советуем также почитать: Почему болит живот при беременности
Повышенная свертываемость крови во время беременности

Совсем недавно, работая над проблемой свертываемости крови, многие известные ученые рассматривали в целом проблему образования тромбов, у тех, кто совершал далекие перелеты или у лежачих больных. Спустя некоторое время, все больше заговорили о том, что тромбофилия тесно связана с осложнениями, которые возникают во время вынашивания малыша.
Ни для кого не секрет, что очень много беременностей заканчиваются выкидышами, из-за того, что у мамы была повышенная свертываемость крови. В большинстве случаев приходится говорить, о генетических дефектах, которые не мешают в обычной повседневной жизни, но они очень опасны во время вынашивания ребенка. Наиболее часто генетические мутации в системе свертываемости крови возникают в Израиле.
Возможно из-за частых браков между родственниками.
Женщины, которые вынашивают малыша, в десять раз больше склонны к повышенной свертываемости крови. Если будущая мама, до зачатия ребенка имела такую проблему, то в период беременности она только усиливается, что приводит к возникновению таких заболеваний как: отслоение плаценты, поздние токсикозы, неправильное развитие плода, внутриутробная смерть малыша, преждевременное родоразрешение.
Если проблема возникает после рождения ребенка, маме обязательно назначают лечение, поскольку риск становится еще больше. В случае, когда у будущей мамы или роженицы образовались тромбы, ей дают препараты, которые разжижают кровь.
Очень важно помнить, что проблему повышенной свертываемости крови необходимо выявить как можно раньше. Сделать это очень просто — необходимо сдать обычный анализ крови в лаборатории.
Кроме анализов, учеными были установлены еще и другие методики, которые способны выявлять женщин, страдающих повышенной свертываемостью крови.
Чтобы не говорили врачи, какие анализы и методики их выявления они не придумывали, каждая женщина должна заботится о своем здоровье, особенно, когда она хочет стать мамой. Ведь со времени зачатия малыша, она несет ответственность не только за свою жизнь, но и за жизнь маленькой крохи.
Если вы не успели пройти обследование перед беременностью — сделайте это на первых неделях вынашивания вашего ребенка. Обратитесь к своему врачу-гинекологу и пройдите всех специалистов. В случае, когда вам скажут о каких-либо отклонениях — не паникуйте, а немедленно пройдите дополнительные обследования.
Ведь это ваша жизнь.
Плохая свертываемость крови при беременности чем грозит ребенку
Период вынашивания ребёнка – серьёзное испытание для женского организма, поэтому на протяжении беременности будущая мама проходит многочисленные анализы и тестирования. После того, как женщина забеременела, важно отслеживать её самочувствие до родов.
Контроль над показателями крови – одно из основных исследований, дающих возможность следить за состоянием здоровья женщины и плода.
А при обнаружении нарушений благодаря частоте проводимых анализов высока вероятность успешного лечения из-за своевременного установления диагноза.
Показатель, на который врачи обращают внимание свертываемость крови. Норма у женщин при беременности на разных этапах меняется, что не всегда означает патологию, но нуждается в контроле.
Как свертываемость крови влияет на беременность
Кровь, циркулирующая по сосудам, выполняет большое количество функций, основной у беременных является транспортная. За счет клеточных элементов через плаценту попадает кислород и питательные вещества, что позволяет нормально формироваться плоду внутри утробы.
В период вынашивания ребенка объем крови значительно увеличивается, поэтому важно оценить ее состояние, понимать с какой скоростью образуется сгусток при повреждении сосудов, необходимо знать насколько густая или жидкая субстанция.
Свертываемость крови влияет на беременность в значительной степени, ведь от этого зависит жизнь не только младенца, но и матери.
Симптоматика
Проявление признаков плохой свертываемости крови будущие матери обычно не замечают в течение достаточно долгого времени. Им кажется, что состояние их здоровья находится на том уровне, которое называется «норма». Но постепенно нарастают патологические изменения в системе свертываемости, и тогда становятся заметными специфические признаки плохой свертываемости у беременной женщины.
При проявлении симптомов патологии у беременной женщины можно заметить довольно заметные подкожные гематомы.
Если даже физическое воздействие было совсем слабым, нередко происходит носовое кровотечение, а с мочой выделяются эритроциты; после того как женщина почистит зубы, на щетке остается кровь.
Помимо этого, на коже начинают появляться микротрещины и ранки, хотя внешнего воздействия на кожные покровы не производилось.
После этих признаков плохой свертываемости крови начинается проявление клинической картины анемии, то есть женщина может становиться слабой, у нее кружится голова, выпадают волосы, ломаются и становятся хрупкими ногти, она мучается запорами или диареей. Нижнее веко глаза имеет бледную слизистую оболочку.
ПОДРОБНОСТИ: Неприятные ощущения в заднем проходе при беременности
На что стоит обратить внимание в первую очередь? Как и любое другое заболевание, повышенная свертываемость крови при беременности сопровождается определенными клиническими проявлениями. Среди наиболее характерных симптомов можно выделить следующие:
- повышенная утомляемость при минимальных физических нагрузках;
- головные боли;
- головокружение и краткосрочные нарушения пространственной ориентации;
- снижение мышечного тонуса;
- сильная тошнота;
- онемение верхних конечностей;
- нарушение сна;
- подавленное состояние, граничащее с депрессией;
- дискомфорт и болевые ощущения в области груди;
- ощущение жжения в глазах;
- аллергия на холод.
Если вы обнаружили у себя хотя бы некоторые из описанных симптомов, то стоит незамедлительно записаться на прием к доктору. Любое промедление может быть чревато очень серьезными последствиями.
Начальная стадия снижения свертываемости крови проходит незаметно, так как нет ярко выраженных симптомов плохой свертываемости крови, которые встревожили бы человека.
Лишь спустя время, можно заметить, что даже мелкие царапинки и ранки долго не заживают, а на коже спонтанно появляются микроскопические трещинки.
При незначительном воздействии появляются обширные гематомы, и держаться длительное время.
При нарушении гемокоагуляции учащаются носовые кровотечения, которые сложно остановить, причем для гемофилии характерны повторяющиеся эпизоды, даже спустя несколько часов после остановки кровотечения. Среди частых и наиболее показательных симптомов плохой свертываемости крови можно выделить появление крови при чистке зубов.
При гемокоагуляции учащается носовое кровотечение
Позже присоединяются признаки и симптомы анемии: бледные кожные покровы и слизистые оболочки глаз, головокружение, быстрая утомляемость, сухость и ломкость волос и ногтей, диспепсические расстройства. При наличии язвенной болезни желудка или двенадцатиперстной кишки существует риск профузных кровотечений. У женщин возможно возникновение экстрагенитальных маточных кровотечений.
При тяжелой форме нарушения системы коагуляции – болезни Виллебранда, образуются характерные подкожные кровоизлияния, часты кровоизлияния в околосуставную сумку, возможны внутренние кровотечения.
Болезнь Виллебранда передается наследственным путем, но существуют и приобретенные формы.
Они возникают после частого переливания крови, как осложнение, могут провоцироваться ревматоидными заболеваниями, некоторыми сердечными патологиями.
Нормы свертываемости крови при беременности
Гемостаз в период 9-ти месячного вынашивания плода претерпевает значительные изменения, поэтому врачи рассчитывают нормы свертываемости крови при беременности. Это является важным показателем стабильного функционирования кровеносной системы, которое не угрожает тромбообразованием или открытием кровотечения.
У женщин 1 триместр характеризуется незначительными изменениями, свертываемость крови остается практически на прежнем уровне, что и до зачатия.
Но уже 2 и 3 триместр обуславливаются повышением, начинается активация внутрисосудистого свертывания крови, организм подготавливается к предстоящему родоразрешению, возрастает риск кровопотери, что потребует от гемостаза своевременного прекращения кровотечения.
Анализ на свертываемость крови при беременности проводится с целью сравнения данных параметров с принятыми нормами:
- АЧТВ – показывает временной промежуток, при котором происходит свертывание крови. Норма несколько снижена в период внутриутробного формирования малыша и показатель может составлять время от 20 секунд;
- Фибриноген – белковое соединение с помощью, которого создается сгусток. Норма – до 6,1 г/л;
- Тромбоциты – клеточные элементы, обеспечивающие нормальный гемостаз, содержатся в крови от 130 до 400 тыс/мкл;
- Протромбин непосредственно участвует в процессе образования сгустка наравне с фибриногеном (75-140%). Дополнительно подсчитывается тромбиновое время – от 18 до 25 секунд.
- Антитромбин III – существенно замедляет образование тромба, в нормальном состоянии не превышает 115%, но и не ниже – 70%.
Любое нарушение или присутствие антиген (волчаночный коагулянт) приводят к тяжелым последствиям, поэтому анализ проводится несколько раз за весь период, чтобы своевременно начать лечение.
Что такое тромбофилия, тромбоэмболия и венозный тромбоэмболизм
Для устойчивого функционирования организма очень важно, чтобы свертываемость крови была в норме, так как при повышенной коагуляции возникает риск образования тромбов, затрудняющих свободный ток крови по сосудам.
Под тромбами понимают патологические кровяные сгустки, формирующиеся при жизни человека в просвете сосуда или сердечной полости. Патологическое состояние, при котором возрастает риск возникновения тромбозов, именуется тромбофилией.
Она может быть врожденной или приобретенной.
Если патологический кровяной сгусток отделяется от стенки сосуда и попадает в кровоток, то он превращается в эмбол, циркулирующий с кровью и способный вызвать острую закупорку просвета сосуда. Такое очень опасное осложнение называется тромбоэмболией.
Когда тромбообразование происходит в венозном русле кровообращения, и тромб переносится током крови дальше по сосудам, говорят о венозном тромбоэмболизме. Наиболее часто это угрожающее здоровью и жизни состояние оказывается представлено тромбозом глубоких вен нижних конечностей с развитием тромбоэмболии легочной артерии.
Чем опасно повышенная свертываемость при беременности
Высокая свертываемость характеризуется проявлением осложнений во время беременности. В сосудах, которые пронизывают плаценту, может появиться сгусток, который приведет к ограничению поступления кислорода, доступ питательных веществ к плоду уменьшится.
Таким образом, повышение гемостаза опасно задержкой развития, формированием пороков, вплоть до самопроизвольного выкидыша. Причины внутриутробной гибели младенца часто состоят в формировании антифосфолипидного синдрома, при котором образуются тромбы, как в артериях, так и в венах.
С целью постановки диагноза определяются антитела к фосфолипидам.
Снизить свертываемость крови при беременности можно с помощью специальной диеты, которая направлена на увеличение потребление жидкости. Рацион питания должен быть максимально сбалансированным, с ограничением по употреблению жареной и жирной пищи.
Сильная свертываемость обуславливает специальное лечение при помощи антикоагулянтов для разжижения крови.
Лечение
Лечит плохое свертывание крови у беременной женщины врач-гематолог. В любых случаях проявления болезни необходимо назначить индивидуальную программу лечения пациентки с тромбоцитопенией, учитывая состояние здоровья будущей матери и имеющихся у нее хронических болезней. Если лечение назначено своевременно, это даст большие шансы на вынашивание женщиной здорового ребенка.
Обычно лекарственные препараты, назначаемые специалистами, настораживают будущих мам, ведь применение лекарств в целом во время беременности крайне нежелательно.
Однако специального рода препараты, повышающие шансы на благоприятные роды, которые назначаются гематологом для нормализации системы крови, не имеют свойств, отрицательно действующих на ребенка и на саму женщину.
Напротив, они помогут повысить шансы на удачное вынашивание малыша и отсутствие сильного кровотечения во время родов.
Лечение плохой свертываемости крови следует проводить только после результатов анализа крови и прохождения полного обследования организма. В зависимости от причины плохой свертываемости крови, вызвавшей это состояние, лечащий доктор подбирает лечение.
Если нарушение свертываемости крови вызвано патологией в желудочно-кишечном тракте, проводится коррекция и лечение органов пищеварительной системы. При заболеваниях печени следует полностью отказаться от употребления алкоголя, при болезнях поджелудочной железы исключить из рациона жирную, острую и жареную пищу.
Важное значение имеет нормализация работы тонкого кишечника, так как усвоение витаминов К и В12 (играющих основную роль в синтезе протромбина и фибриногена) происходит именно там. Поступление этих витаминов в организм в достаточном количестве должно обеспечить полноценное правильное питание, для этого требуется пересмотреть свой рацион.
Содержание витамина К в продуктах
Беременной женщине крайне важно поддерживать нормальный уровень свертывания крови и делать это, по возможности, не медикаментозными средствами. Все лекарственные препараты женщина «в положении» должна принимать строго по предписанию врача. Самостоятельно можно лишь подкорректировать список употребляемых продуктов.
Внутренние кровотечения, особенно скрытые, серьезно изменяют картину крови. При подозрении требуется тщательное обследование и скорейшее выявление данного факта.
Не менее точное обследование необходимо и при вероятности развития онкологических заболеваний. В данном случае потребуется длительное лечение и, к сожалению, в процессе лечения страдает картина состава крови в целом и система свертывания, в частности.
ПОДРОБНОСТИ: Анализ ХГЧ при беременности: зачем сдавать, уровни ХГЧ по неделям и их расшифровка
В специализированном лечении и поддерживающей терапии нуждаются люди с врожденными дефектами гемокоагуляции. Например, при болезни Виллибранда и при гемофилии пациентам проводится периодическое переливание необходимых компонентов крови, которые выделяют из донорской крови.
В тяжелых случаях нарушения тромбообразования, возможно введение синтетических препаратов, аналогов витаминов К и В12, которые стимулируют выработку протромбина и фибриногена. В комплексной терапии назначают препараты, понижающие проницаемость кровеносных сосудов.
Препараты протромбинованного комплекса
Чем грозит плохая свертываемость крови при беременности
Низкая свертываемость у беременных грозит преждевременной отслойкой плаценты, а также кровотечением при родах. Несвертываемость не редко возникает по причине недостаточного иммунитета, состояние опасно для жизни женщины и для ребенка.
Только в первые три месяца допускается пониженная норма параметров, длительное состояние разжиженности требует детального исследования причин. Последствия отсутствия лечения приводят к развитию пороков и, в худшем варианте, к летальному исходу.
Поэтому назначается специальная медикаментозная терапия с целью коррекции гемостаза. При этом рацион питания исключает употребление пряных и острых блюд, а также отказаться от обильного питья, алкоголя и табакокурения.
Чтобы насытить организм кислородом рекомендуется длительные прогулки на свежем воздухе и посильная физическая нагрузка.
Основные методы терапии
Давайте на этом остановимся более подробно. Слишком высокая вязкость крови может быть связана со множеством факторов.
С одной стороны, может показаться, что ничего страшного при этом нет, однако, данная патология представляет большую угрозу для здоровья и жизни малыша.
Как уже упоминалось ранее, причины повышенной свертываемости крови при беременности могут быть различными. Среди основных профилированные специалисты выделяют следующие:
- нарушение функционирования свертывающей системы;
- сильная интоксикация организма;
- сахарный диабет;
- отек легких;
- дисфункция почек;
- длительный прием некоторых препаратов;
- плохое или нерегулярное питание;
- заболевание инфекционной или вирусной этиологии;
- генетическая предрасположенность;
- ферментопатия;
- амилоидная дистрофия;
- патологии кровеносных сосудов;
- последствия перенесенных операций.
Помимо всего вышеперечисленного, повышенная свертываемость крови при беременности может быть следствием неправильного образа жизни. Поэтому очень важно, чтобы будущая мама пристально следила за своим здоровьем и оберегала себя от любых негативных факторов и стрессовых ситуаций.
Давайте рассмотрим их более подробно. Лечение повышенной свертываемости крови при беременности необходимо начинать как можно скорее, поскольку это состояние представляет большую опасность для здоровья и жизни будущей мамы и ее малыша. Программу терапии подбирает квалифицированный специалист в зависимости от клинической картины и состояния здоровья женщины.
- качественно и сбалансировано питаться;
- отказаться от употребления табачных и алкогольных изделий;
- пить каждый день не менее 2 литров воды;
- делать зарядку и стараться не сидеть подолгу без дела;
- готовить пищу без соли.
Все эти меры позволят повысить эффективность терапии и снизить вероятность развития гиперкоагуляции, поэтому их также можно придерживаться с целью профилактики заболевания.
В целом плохой свертываемостью крови называют патологию, когда наблюдается явление ферментативной недостаточности реагенных свойств фибрина и протеолитических веществ.
Нередко обсуждаются вопросы о том, как правильно назвать данное заболевание. Это связано с тем, что у такого состояния действительно не одно название, а несколько различных наименований.
Так, например, существует такое название плохой свертываемости крови, как тромбоцитопения. В данном случае основной патогенный фактор заключается в том, что недостаточно продуцируются тромбоциты. Если же наличие обильных кровотечений связано с недостатком фибриногена, то этот вид плохой свертываемости крови называют фибронопенией.
В организме беременной женщины начинаются сложнейшие гормональные и иммунные перестройки. Чаще всего нарушенная работа иммунной системы и провоцирует у будущей матери появление такого состояния, как плохая свертываемость крови.
Ведь иммунитет беременных подавлен организмом с той целью, чтобы не отторгался ребенок, у которого генетическая структура белков не такая, как у матери, и воспринимается иммунитетом как инородная.
Иногда это является хорошим средством для избежания неприятных последствий типа геморроя, тромбофлебита, варикозного расширения вен на ногах. Однако когда пройден определенный порог сниженной продукции тромбоцитов, тогда плохая свертываемость крови у беременной женщины становится опасной для нее.
В первую очередь опасно тем, что появляется риск возникновения отслойки плаценты при позднем сроке, профузного кровотечения в родах, преждевременных родов и прерывания беременности вследствие того, что нарушается гемодинамика в области плаценты и пуповины.
При этом, конечно, необходима коррекция, однако осуществлять ее нужно только при тщательном осмотре и руководстве лечащего врача.
( 2 оценки, среднее 4 из 5 )![]()
Плохая свертываемость крови при беременности
Обновлено: 10 часов назад
11 неделя
И ещё одна неделя закончилась. Токсикоз понемножку отпускает, уже не каждый день, хотя все равно бывает очень плохо. Через полторы недели скрининг. Жду очень)
Я вот думаю: сейчас принимаю утрожестан, у него в противопоказаниях значится варикоз.
Собственно варикоза у меня нет, но на одной ноге с венами не все в порядке..
Сдавать кровь на показатели свертываемости, или нет?
В прошлую беременность анализы брали в ЖК и все показатель были в норме, но закончилось все не очень хорошо.. Надо ещё подумать….
Читать далее →
Низкий рост хгч. Замершая… Попытка номер 2
В мае последние месячные и уже в июне я вижу 2 полоски. Радость и страх! Прошло мало времени после операции (в предыдущем посте). Начинаю мониторить хнч конечно же. 10.06 — 24. 13.06-117. 19.06 — 1300, рос нормально, все хорошо, думала я… сдала 26.06….. Читать далее →
Гематолог: мутации фолатного цикла, тромбофилии, антитела к кардиолипину,
Ну что ж. 19.07 сдала анализы. Имею мутации в гетерозиготном носительстве MTR2756, MTR66, ген F13A1(фактор 13), ген Серпин1 (PAI-1). Мутации в гомозиготном носительстве MTHFR677 и ген FGB- Фибриноген (фактор 1). В моем понимании все очень плохо . Потому ….. Читать далее →
Ну вот опять!
Сходила я в жк сегодня. Жесть, конечно, но буду писать по порядку. 1. Выделения розового цвета неипрекратились и их не было только последние два дня.
2. Все чаще был тонус по вечерам. Буквально на несколько секунд, но тем не менее.
3.
С утра болел низ живота.
4. Анализы у меня плохие. И свертываемость крови вроде не такая и гемоглобин низкий. Да и мазок вроде плохой.
5. Меня направили на плановую госпитализацию и лежу я теперь в отделении паталогии беременности в…
Читать далее →
получила выписку…одна тоска
ну что, сходила я вчера и забрала свою выписку и гистологию… как всегда в гистологии ничего не написано, за то анализ крови посмотрела и немного в шоке…
на момент моей беременности гемоглобин был 109, мне выписала моя Г Ферлатум Фол пить, и я честно пила, так вот сейчас гемоглобин 128!!! хотя я уже больше месяца этот препарат не пью… странно всё это.
вообще у меня анемия 1й степени, с рождения, в первую беременность вообще беда была.
ну так вот, еще… Читать далее →
Антитела во время беременности
Долго размышляла, стоит ли писать сейчас про антитела и конфликты по системам крови во время беременности….. Читать далее →
Купить Eltrombopag таблетки онлайн в США — оптовый поставщик медицины
Элтромбопаг Таблетка является рецептурным препаратом. Он поставляется в виде пероральной таблетки и пероральной суспензии.
Пероральная таблетка Eltrombopag доступен как фирменный препарат Promacta. Это не доступно как непатентованный препарат.
Этот ….. Читать далее →
12 +3 неделька беременности
Привет всем, девочки!! ???? Ну что пора рассказать как у меня дела)
За это время меня отправили на пересдачу анализа на свертываемость, оказалось что действительно плохая светрываемость(( направили к гематологу, который только 22 марта сможет меня принять ….. Читать далее →
Беременность и клексан. Длинная дорога к счастью
Добрый день! Когда-то давно, дала себе обещание, если появится ребенок, обязательно напишу свою историю☺️. Долго искала про клексан форумы, толком ничего не нашла Я Вышла замуж в 2014 году, взяли ипотеку -убитую вторичку, начали ремонт и через год решили….. Читать далее →
Как щитовидка влияет на женское здоровье.
Щитовидной железе посвящено немало исследований. Известно, что от правильности её работы зависит очень многое, особенно женское здоровье, в том числе репродуктивная функция. Читать далее →
Дыня при беременности
Дыня — бахчевая культура, относящаяся к семейству Тыквенные, вид рода Огурец. Ее родиной считается Средняя Азия и Малая Азия.
Эта культура любит тепло и свет, устойчива к засухе и засолению почвы, негативно переносит повышенную влажность воздуха. В зависи….. Читать далее →
Варикоз, низкий ферритин и «Лебединое озеро»
Девочки, всем привет ! Значит дело было так. Рассказываю по порядку. Пошла я когда-то давно, ещё в ноябре к терапевту. И говорю ей: а у меня сеточка на ногах и синяки плохо заживают.
Она, естессно: А откуда у вас синяки? А я: А я на работе по кабинету бегаю, об тумбочки стукаюсь, оттуда и синяки. 🙂 И заживают неделями потом. Ага. Она меня и послала. В гематологический центр. Но попала я туда только в феврале.
Праздники там новогодние …то, сё…Сдала анализы… Читать далее →
Беременность при полиморфизме гена фолатного цикла
Я родила со второй попытки. Многие годами планируют, не могут найти причину. Мне повезло встретить своего доктора Бывальцеву Наталью Юрьевну. Она смогла докопаться до причины, устранить ее. Щитовидная железа и генные мутации.
Щитовидка тянет за собой такие явления как сбивчивый цикл, короткую вторую фазу, овуляция плохо отслеживается на графиках базальной температуры, повышен ттг, пролактин, макропролактин.
Генная мутация в гене mtfhr не дает фолиевой кислоте усваиваться, а как известно она крайне важна в первом триместре, когда все закладывается. Отсюда пороки развития… Читать далее →
Полное предлежание плаценты
Привет всем. Думала отсидеться в кустах и просто за всеми понаблюдать, но как-то не получилось. Все шло слишком хорошо и я расслабилась. Не было токсикоза, болей, выделений. Первый триместр прошел на ура! Проблема пришла от куда не ждали.
С мужем обсудить не получается, у него стразу такой страх возникает за меня и малыша, что я даже не буду этой темы касаться. Родителей и его маму пугать не хочется, они очень долго внука ждали, омрачать им ожидание последнее дело.
Еще на…
Читать далее →
недоношенный малыш в реанимации
здравствуйте. хочу поделиться историей своей второй беременности. хочу найти поддержку среди тех, кто пережил подобное. О беременности узнала в апреле. Это была большая радость для нас, потому что у мужа проблемы с гормонами и зачать ребенка в нашем случ….. Читать далее →
Второй раз…
Никогда бы не подумала, что мой второй раз будет настолько отличаться от первого.
Первая беременность была идеальна. Мне 24 года и я в основном здорова. За всю беременность у меня один неудачный анализ — свертываемость крови высокая, пью курантил и кардиомагнил.
Один раз меня тошнит и на лице появляются красные точки лопнувших сосудов. И всего один раз (накануне родов) у меня поднимается давление — вместо постоянных 120/80 — 140/90. Еду в роддом с давлением, вечером меня туда кладут, а ночью…
Читать далее →
История моих родов
Я решила написать эту историю, чтобы рассказать о нескольких врачах, а не конкретно моей истории.
И так… Началось все с того, что мы с мужем наконец-то решились на третьего ребенка. Проблем с тем, чтобы забеременеть у нас вроде как никогда не было. В э….. Читать далее →
Осложнения после родов
Долго собиралась об этом написать.. О беременности и родах, о ГВ легко было писать. Легко писать, когда все хорошо…
Почему-то все статьи и посты, что я встречала о послеродовом периоде, были о детях, об уходе, об их осложнениях, проблемах, болезнях, ре….. Читать далее →
Анализ на гемостаз при планировании беременности
При планировании и во время беременности женщине необходимо сделать гемостазиограмму — анализ, выявляющий нарушения в системе крови. Почему при гемостазе происходит угроза выкидыша и бесплодия? Консультируют врачи-специалисты Седа Баймурадова и Нонна Овсепян.
Кто в «группе риска»?
Свертывающая система крови (гемостаз) нужна для того, чтобы избежать значительных кровопотерь при повреждении сосудов. Вспомните, к примеру — если вы порезали палец, сначала кровь из раны идет сильно, потом останавливается, а вскоре на месте раны образуется корочка — тромб.
В противовес свертывающей системе крови… Читать далее →
Аллергия. Наша история
Всем доброго дня!
Хочется уже внести ясность в наш диагноз и понять, что нам дальше делать!
Ну и для себя оставить, на память(((
Понятное дело, что лечение по Интернету — это зло, но пока лечение у врачей устойчивого результата или какой-то ясности не пр….. Читать далее →
Советы после неудавшегося ЭКО
Советы женщинам после неудавшегося ЭКО
Вся информация взята с сайта: https://s-nadejdoy.ru/vse-ob-eko/206-sovety-zhenshchinam-posle-neudavshegosya-eko … Читать далее →